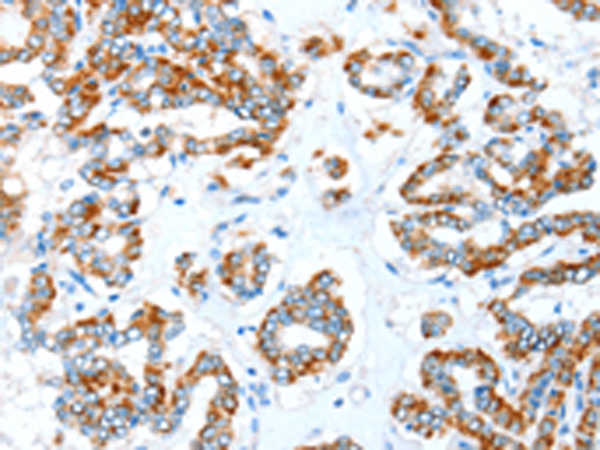
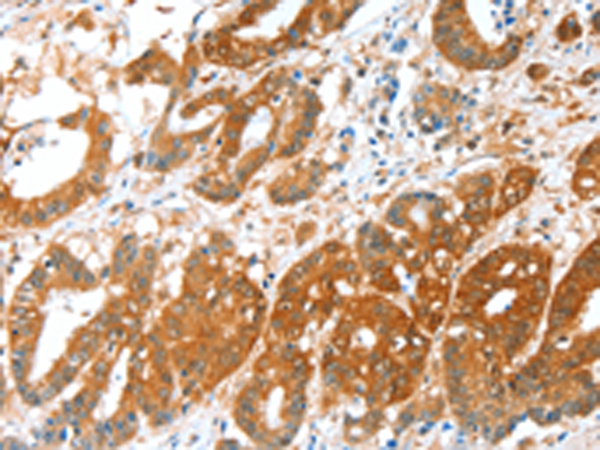

-
分类: 科研抗体货号: P11445别名: CDG1C应用: WB反应种属: Human, Mouse, Rat
-
分类: 科研抗体货号: P11426别名: VWFCP; C9orf8; vWF-CP; ADAM-TS13; ADAMTS-13应用: IHC反应种属: Human
-
分类: 科研抗体货号: P11444别名: ALDB; ALDO2应用: WB,IHC反应种属: Human, Mouse, Rat
-
分类: 科研抗体货号: P11425别名: MLTNB; FKSG34; MADDAM应用: IHC反应种属: Human, Mouse
-
分类: 科研抗体货号: P11443别名: E3; ALDH4; ALDH7; ALDH9; TMABADH应用: WB,IHC反应种属: Human, Mouse, Rat
-
分类: 科研抗体货号: P11424别名: MCMP; MLTN; CAR10; MLTNA; MCMPMltna; ADAM12-OT1应用: IHC反应种属: Human, Mouse
-
分类: 科研抗体货号: P11441别名: SSDH; SSADH应用: IHC反应种属: Human, Mouse, Rat
-
分类: 科研抗体货号: P11423别名: MDC应用: WB,IHC反应种属: Human, Mouse
-
分类: 科研抗体货号: P11440别名: ALDH5; ALDHX应用: IHC反应种属: Human
-
分类: 科研抗体货号: P11422别名: ADA2; ADA2A; KL04P; hADA2; TADA2L应用: IHC反应种属: Human, Mouse, Rat

鄂公网安备42018502007531号
鄂公网安备42018502007531号

